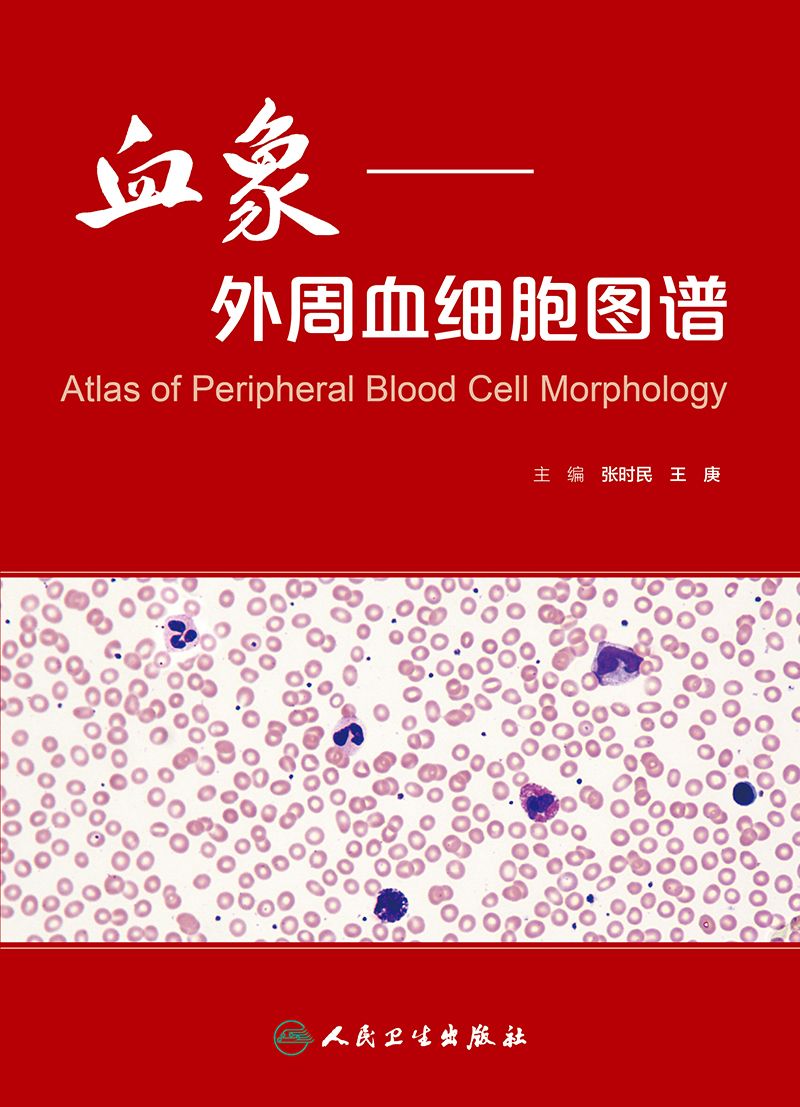
血象——外周血细胞图谱

编辑推荐
以血细胞形态显微镜筛检,程序、规则、要求、做法和经验为主,面向广大一线检验工作者。
内容简介
以外周血液细胞形态为主,注重常规工作中常见问题。据这一特点,针对这一空白区域,编写一部有价值的参考工具书。本书的特色是将从血液细胞形态检验的基本程序开始,以图配合文字的方式介绍正常情况下的细胞形态,常见的病理情况下的细胞形态,各种特殊病例情况下的细胞形态改变等。并列举常见病例以及仪器分析结果与形态学检验之间的关系等,进行深入浅出的描述。
展开全文
- 版权页
- 主编简介
- 主编简介
- 序
- 前 言
- 绪 论
- 血细胞分析自动化与显微镜复检应关注的问题
- 第一章 血片制备
- 一、血涂片的制备
- 二、染色
- 三、血涂片的观察方法
- 四、如何进行血涂片复检
- 第二章 红系统细胞形态
- 一、正常红细胞
- 二、红细胞大小改变
- 1.小红细胞(microcyte)
- 2.大红细胞(macrocyte)
- 3.巨红细胞(megalocyte)
- 4.红细胞大小不均(anisocytosis)
- 三、红细胞血红蛋白含量改变
- 1.正常色素性(normochromic)
- 2.低色素性(hypochromic)
- 3.高色素性(hyperchromic)
- 4.嗜多色性(polychromatic)
- 5.细胞着色不一(anisochromia)
- 四、红细胞形态改变
- 1.球形红细胞(spherocyte)
- 2.椭圆形红细胞(elliptocyte)
- 3.靶形细胞(target cell)
- 4.半岛形细胞
- 5.口形细胞(stomatocyte)
- 6.镰形细胞(sickle cell)
- 7.棘形细胞(acanthocyte)
- 8.刺红细胞/锯齿状红细胞(echinocyte)
- 9.泪滴形红细胞(tear drop cell)
- 10.裂红细胞(schistocyte)
- 11.红细胞形态不整(poikilocytosis)
- 12.固缩红细胞(pyknocyte)
- 13.咬痕红细胞(bite cell,degmacyte)
- 14.皱缩红细胞(crenated cell)
- 五、红细胞内结构异常
- 1.嗜碱性点彩红细胞(basophilic stippling cell)
- 2.豪焦小体(Howell-Jolly’s body)
- 3.卡波环(Cabot ring)
- 4.有核红细胞(nuclear RBC)
- 5.细胞有丝分裂
- 6.帕彭海默小体(Pappenheimer bodies)
- 7.网织红细胞
- 六、红细胞内异常血红蛋白
- 1.血红蛋白H症时红细胞内包涵体
- 2.海恩茨小体(Heniz bodise)
- 七、红细胞分布和排列情况
- 1.正常人红细胞分布
- 2.贫血患者红细胞分布
- 3.红细胞增多患者红细胞分布
- 4.真性红细胞增多症患者红细胞分布
- 5.缗钱状形成(rouleaux formation)
- 6.红细胞凝集(hemagglutination)
- 八、外观和涂片观察
- 1.乳糜血和脂血
- 2.冷凝集现象
- 3.高胆红素标本
- 4.溶血标本
- 5.高白细胞标本外观和血片
- 第三章 白系统细胞形态
- 一、正常白细胞形态
- 1.中性分叶核粒细胞(neutrophilic segmented granulocyte)
- 2.中性杆状核粒细胞(neutrophilic stab granulocyte)
- 3.核分叶过多(hypersegmentation)
- 4.中性粒细胞鼓槌小体(neutrophil drumstick)
- 5.嗜酸性粒细胞(eosinophil granulocyte)
- 6.嗜碱性粒细胞(basophil granulocyte)
- 7.淋巴细胞(lymphocyte)
- 8.单核细胞(monocyte)
- 二、中性粒细胞毒性变化
- 1.细胞大小不均(anisocytosis)
- 2.中毒颗粒(toxic granulation)
- 3.空泡形成(vacuolation)
- 4.杜勒小体(Döhle body)
- 5.退行性变(degeneration)
- 三、其他中性粒细胞异常形态
- 1.多颗粒(hypergranulation)与少颗粒(hypogranulation)中性粒细胞
- 2.少颗粒中性粒细胞及髓过氧化物酶缺乏(hypogranulation and pulp peroxidase deficiency)
- 3.巨大杆状核中性粒细胞(gaint stab granulocyte)
- 4.双核中性粒细胞(double nucleus neutrophil)
- 5.巨多分叶核中性粒细胞(giant hypersegmentation)
- 四、与遗传病有关的形态异常
- 1.Pelger-Huët畸形(Pelger-Huët anomaly)
- 2.Chediak-Higashi畸形(Chediak-Higashi anomaly)
- 3.Alder-Reilly畸形(Alder-Reilly anomaly)
- 4.May-Hegglin畸形(May-Hegglin anomaly)
- 五、异形淋巴细胞
- 1.Ⅰ型异形淋巴细胞
- 2.Ⅱ型异形淋巴细胞
- 3.Ⅲ型异形淋巴细胞
- 六、其他淋巴细胞形态异常
- 1.淋巴细胞微核(micronucleus of lymphocyte)
- 2.双核淋巴细胞(double nucleus lymphocyte)
- 3.花瓣核淋巴细胞和退化淋巴细胞
- 七、浆细胞
- 八、其他异常
- 1.红斑狼疮细胞
- 2.白细胞吞噬真菌
- 3.白细胞聚集
- 4.浆质体
- 5.陈旧血中退化细胞
- 九、血涂片白细胞分布密度评估
- 第四章 血小板形态
- 一、正常血小板形态
- 二、异常血小板形态
- 1.大小异常
- 2.血小板形态异常
- 3.血小板颗粒减少(hypogranular platelet)
- 4.血小板卫星现象
- 5.血小板“黏附”红细胞
- 三、血小板聚集性和分布情况
- 1.聚集性和分布异常
- 2.血小板减少(thrombocytopenia)
- 3.血小板正常
- 4.血小板增多(thrombocytosis)
- 5.血小板功能异常
- 6.血小板聚集(platelet aggregation,platelet clump)
- 7.纤维蛋白夹裹血小板形成的轻度凝集现象
- 8.白细胞吞噬血小板现象
- 9.冷球蛋白致血小板假性升高现象
- 第五章 常见血液系统疾病外周血细胞形态
- 一、急性髓系白血病
- 1.急性髓系白血病,未分化型(M1型)
- 2.急性髓系白血病,部分分化型(M 2型)
- 3.急性早幼粒细胞白血病(M3型)
- 4.急性粒-单核细胞白血病(M4型)
- 5.急性单核细胞白血病(M5型)
- 6.急性红白血病(M6型)
- 7.急性巨核细胞白血病(M 7型)
- 二、急性淋巴细胞白血病
- 1.急性淋巴细胞白血病(L1型)
- 2.急性淋巴细胞白血病(L2型)
- 3.急性淋巴细胞白血病(L3型)或Burkitt淋巴瘤
- 三、慢性骨髓增殖性疾病
- 1.慢性粒细胞白血病(chronic myelogenous leukemia,CML)
- 2.慢性粒单核细胞白血病(chronic myelomonocytic leukemia,CMML)
- 3.骨髓纤维化(bonemarrow fibrosis,BMF)
- 四、淋巴瘤
- 1.慢性淋巴细胞白血病(chronic lymphocytic leukemia,CLL)与幼淋巴细胞白血病(prolymphocytic leukemia,PLL)
- 2.毛细胞白血病(hairy cell leukemia)与脾边缘带淋巴瘤(splemic marginal zone lymphoma,SMZL)
- 3.成人T细胞白血病/淋巴瘤(adult T-cell leukemia/lymphoma,ATL)
- 4.Sézary syndrome的SS细胞(Sézary cell)
- 5.多发性骨髓瘤和浆细胞白血病(plasma cell leukmia)
- 6.恶性淋巴瘤
- 7.尼曼-匹克病
- 8.骨髓增生异常综合征
- 第六章 血液寄生虫
- 一、疟原虫
- 1.间日疟原虫(plasmodium vivax)
- 2.恶性疟原虫(plasmodium falciparum)
- 3.三日疟原虫(plasmodium malariae)
- 4.卵形疟原虫(plasmodium ovale)
- 二、丝虫
- 三、锥虫
- 1.冈比亚锥虫或罗德西亚锥虫(图6-55~图6-58)。
- 2.枯氏锥虫(图6-59~图6-62)。
- 四、巴贝西虫
- 参考文献
- 附录1 全国血液学复检专家小组工作会议纪要暨血细胞自动计数复检标准释义
- 一、国际血液学复检专家组推荐的41条自动血细胞计数(cell blood count,CBC)和白细胞分类计数(differential blood count,DBC)复检规则
- 1.新生儿
- 2.WBC、RBC、Hb、PLT、网织红细胞(Ret)
- 3.WBC、PLT
- 4.WBC、RBC、Hb、PLT
- 5.WBC
- 6.WBC
- 7.PLT
- 8.PLT
- 9.Hb
- 10.MCV
- 11.MCV
- 12.MCV
- 13.MCHC
- 14.MCHC
- 15.红细胞体积分布宽度(RDW)
- 16.无白细胞分类计数(DC)结果或Dc结果不全
- 17.中性粒细胞绝对计数(Neut#)
- 18.淋巴细胞绝对计数(Lym#)
- 19.单核细胞绝对计数(Mono#)
- 20.嗜酸性粒细胞绝对计数(Eos#)
- 21.嗜碱性粒细胞绝对计数(Baso#)
- 22.有核红细胞绝对计数(NRBC#)
- 23.网织红细胞绝对计数(Ret#)
- 24.怀疑性报警[不成熟粒细胞(IG)/杆状核中性粒细胞(Band)报警提示除外]
- 25.怀疑性报警
- 26.WBC结果不可靠报警
- 27.RBC碎片
- 28.双形RBC
- 29.难溶性RBC
- 30.PLT聚集报警
- 31.PLT报警
- 32.IG报警
- 33.IG报警
- 34.左移报警
- 35.不典型和(或)变异Lym
- 36.不典型和(或)变异Lym
- 37.原始细胞报警
- 38.原始细胞报警
- 39.原始细胞报警
- 40.NRBC报警
- 41.Ret
- 二、国际血液学复检专家组推荐的41条自动CBC和DC复检规则专业术语释义
- 1.涂片镜检(slide review)
- 2.人工分类(manual differential)
- 3.Delta check定义
- 4.Delta限
- 5.Delta值通过和超限
- 6.阳性和阴性Delta
- 7.Delta值超限后所采取的措施
- 8.IG/Band报警提示除外
- 9.如需要,进行人工分类
- 附录2 五分类法血细胞分析仪进展和散点图解读
- 一、电阻抗法仪器的主要技术进步和所解决的问题
- 1.扫流技术
- 2.防反流装置
- 3.三次计数技术或多段计数技术
- 4.脉冲编辑功能
- 5.重叠校正
- 6.延时计数
- 7.浮动界标
- 8.拟合曲线
- 9.鞘流技术
- 10.细胞分群技术
- 二、血细胞分析仪五分类技术
- 三、主要类型的血细胞分析仪测定原理和白细胞分类散点图解读
- 1.LH780型血细胞分析仪测定原理及散点图解析
- 2.XE-5000型血细胞分析仪测定原理及散点图解析
- 3.Advia2120i型血细胞分析仪测定原理及散点图解析
- 4.PENTRA DX 120型血细胞分析仪测定原理及散点图解析
- 5.BC-6800型血细胞分析仪测定原理及散点图解析
- 6.CD Sapphire血细胞分析仪测定原理及散点图解析
- 四、小结
- 附录3 多种型号血细胞分析仪(五分类法)报警信息及含义解读
- 附录4 ICSH推荐的外周血细胞形态特征命名和分级标准化的建议
展开全部
版权信息
出版社:人民卫生出版社
出版时间:2016
作者:张时民
温馨提示:
1.本电子书已获得正版授权,由出版社通过知传链发行。
2.该电子书为虚拟物品,付费之后概不接收任何理由退款。电子书内容仅支持在线阅读,不支持下载。
3.您在本站购买的阅读使用权仅限于您本人阅读使用,您不得/不能给任何第三方使用,由此造成的一切相关后果本平台保留向您追偿索赔的权利!版权所有,后果自负!
得书感谢您对《血象——外周血细胞图谱》关注和支持,如本书内容有不良信息或侵权等情形的,请联系本网站。
出版时间:2016
作者:张时民
温馨提示:
1.本电子书已获得正版授权,由出版社通过知传链发行。
2.该电子书为虚拟物品,付费之后概不接收任何理由退款。电子书内容仅支持在线阅读,不支持下载。
3.您在本站购买的阅读使用权仅限于您本人阅读使用,您不得/不能给任何第三方使用,由此造成的一切相关后果本平台保留向您追偿索赔的权利!版权所有,后果自负!
得书感谢您对《血象——外周血细胞图谱》关注和支持,如本书内容有不良信息或侵权等情形的,请联系本网站。